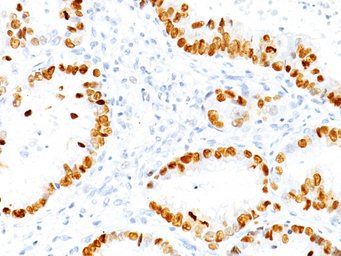
产品细节图片2

相关产品推荐更多 >
万千商家帮你免费找货
0 人在求购买到急需产品
- 详细信息
- 文献和实验
- 技术资料
- 免疫原:
Recombinant TTF-1 protein
- 亚型:
IgG1
- 形态:
Liquid
- 保存条件:
Store as concentrated solution. Centrifuge briefly prior to opening vial. For short-term storage (1-2 weeks), store at 4ºC. For long-term storage, aliquot and store at -20ºC or below. Avoid multiple freeze-thaw cycles.
- 克隆性:
Monoclonal
- 标记物:
Unconjugated
- 适应物种:
Human, Mouse, Rat
- 保质期:
12 months from the shipping date of the product.
- 目录编号:
GTX34906
- 级别:
Primary Antibodies
- 库存:
Available
- 供应商:
GeneTex
- 宿主:
Mouse
- 应用范围:
ICC/IF, IHC-P, FACS
- 浓度:
0.2 mg/ml (Please refer to the vial label for the specific concentration.)
- 靶点:
NKX2.1
- 抗体英文名:
NKX2.1 antibody [NX2.1/690]
- 抗体名:
NKX2.1 抗体 [NX2.1/690]
- 规格:
100 μg

IHC-P analysis of rat lung tissue using GTX34906 NKX2.1 antibody [NX2.1/690].
IHC-P analysis of human lung adenocarcinoma tissue using GTX34906 NKX2.1 antibody [NX2.1/690].

IHC-P analysis of human thyroid tissue using GTX34906 NKX2.1 antibody [NX2.1/690].
风险提示:丁香通仅作为第三方平台,为商家信息发布提供平台空间。用户咨询产品时请注意保护个人信息及财产安全,合理判断,谨慎选购商品,商家和用户对交易行为负责。对于医疗器械类产品,请先查证核实企业经营资质和医疗器械产品注册证情况。
 文献和实验
文献和实验7.5, 150 mM NaCl, and1% (v/v) Triton X-100. 7. Suitable SDS-PAGE and transfer setup as in Section 2.4.1 . 8. Protein Sample Loading Dye (4×) as in Section 2.4.1 . 9. Nitrocellulose or PVDF membrane. 10. Mouse anti-β-catenin antibody (available
逃逸。在非小细胞肺癌中,PD-L1 的表达水平是预测免疫检查点抑制剂疗效的关键生物标志物[1]。 图 1. 人肺癌组织的 PD-L1 免疫组化分析[2]。 TTF-1 TTF-1——甲状腺转录因子-1,属于 NKX2 转录因子家族。 定位:细胞核。 功能:TTF-1 是调控肺组织和甲状腺器官特异性基因表达的核转录因子,对肺泡上皮细胞的终末分化和表面活性物质的分泌至关重要。 TTF-1 是关键的核转录因子,表达具有高度组织特异性。它在肺腺癌和甲状
) Construction of a semisynthetic antibody library using trinucleotide oligos. Nucleic Acids Res. 25, 4690, 4691. 14. Gaytan, P. , Yanez,J . ,Sanchez, F . , and Soberon, X. ( 20 0 1 ) Orthogonal combinatorial mutagenesis:
 技术资料
技术资料暂无技术资料 索取技术资料







![GSS antibody [1A12]](https://img1.dxycdn.com/2022/0328/544/5771933757548500453-14.jpg!wh200)
![CD19 antibody [LT19] (PE)](https://img1.dxycdn.com/2022/0328/338/2857117545428300453-14.jpg!wh200)


